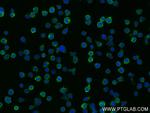
Fas/CD95 Antibody in Immunocytochemistry (ICC/IF)
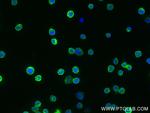
Fas/CD95 Antibody in Immunocytochemistry (ICC/IF)

Search
Proteintech
Fas/CD95 Recombinant Rabbit Monoclonal Antibody (240340E11)
{{$productOrderCtrl.translations['antibody.pdp.commerceCard.promotion.promotions']}}
{{$productOrderCtrl.translations['antibody.pdp.commerceCard.promotion.viewpromo']}}
{{$productOrderCtrl.translations['antibody.pdp.commerceCard.promotion.promocode']}}: {{promo.promoCode}} {{promo.promoTitle}} {{promo.promoDescription}}. {{$productOrderCtrl.translations['antibody.pdp.commerceCard.promotion.learnmore']}}
产品信息
83400-5-RR
种属反应
宿主/亚型
Expression System
分类
类型
克隆号
抗原
偶联物
形式
浓度
规格
纯化类型
保存液
内含物
保存条件
运输条件
靶标信息
CD95, also known as Fas or APO-1, is a 46 kDa transmembrane glycoprotein that functions as a cell death receptor in the tumor necrosis factor receptor (TNFR) superfamily. It is expressed by a wide range of hematopoietic and non-hematopoietic cells, including monocytes, neutrophils, lymphocytes, and fibroblasts. CD95 also exists in a soluble form weighing approximately 26 kDa. The interaction of CD95 with its ligand, FasL, induces apoptosis, playing a crucial role in peripheral tolerance and anti-viral immune responses. Upon stimulation, CD95 leads to the aggregation of its intracellular Fas-associated death domains (FADD), formation of the death-inducing signaling complex (DISC), and activation of caspases. This cascade results in apoptosis. CD95 is also involved in activating NF-kappaB, MAPK3/ERK1, and MAPK8/JNK, and transduces proliferative signals in normal diploid fibroblasts and T cells. There are at least eight alternatively spliced transcript variants encoding seven distinct isoforms of CD95. Isoforms lacking the transmembrane domain may negatively regulate apoptosis mediated by the full-length isoform. The Fas/Fas ligand system is implicated in several human diseases, including AIDS, hepatitis, and cancer, highlighting its importance in immune regulation and disease pathology.
仅用于科研。不用于诊断过程。未经明确授权不得转售。
篇参考文献 (0)
生物信息学
蛋白别名: 774delG; 943dupG; Apo-1 antigen; APO-1 cell surface antigen; Apo-1 Fas; Apo1 antigen; apoptosis antigen 1; apoptosis signaling receptor FAS; Apoptosis-mediating surface antigen FAS; CD95; CD95 antigen; FAS; Fas (TNF receptor superfamily, member 6); Fas AMA; FAS9; FASLG receptor; mutant tumor necrosis receptor superfamily member 6; OTTHUMP00000020045; OTTHUMP00000020046; OTTHUMP00000020051; OTTHUMP00000059646; TNF receptor superfamily member 6; TNFRSF6; Tumor necrosis factor receptor superfamily member 6; tumor necrosis factor receptor superfamily, member 6; unnamed protein product
基因别名: ALPS1A; APO-1; APT1; CD95; FAS; FAS1; FASTM; TNFRSF6
UniProt ID: (Human) P25445
Entrez Gene ID: (Human) 355